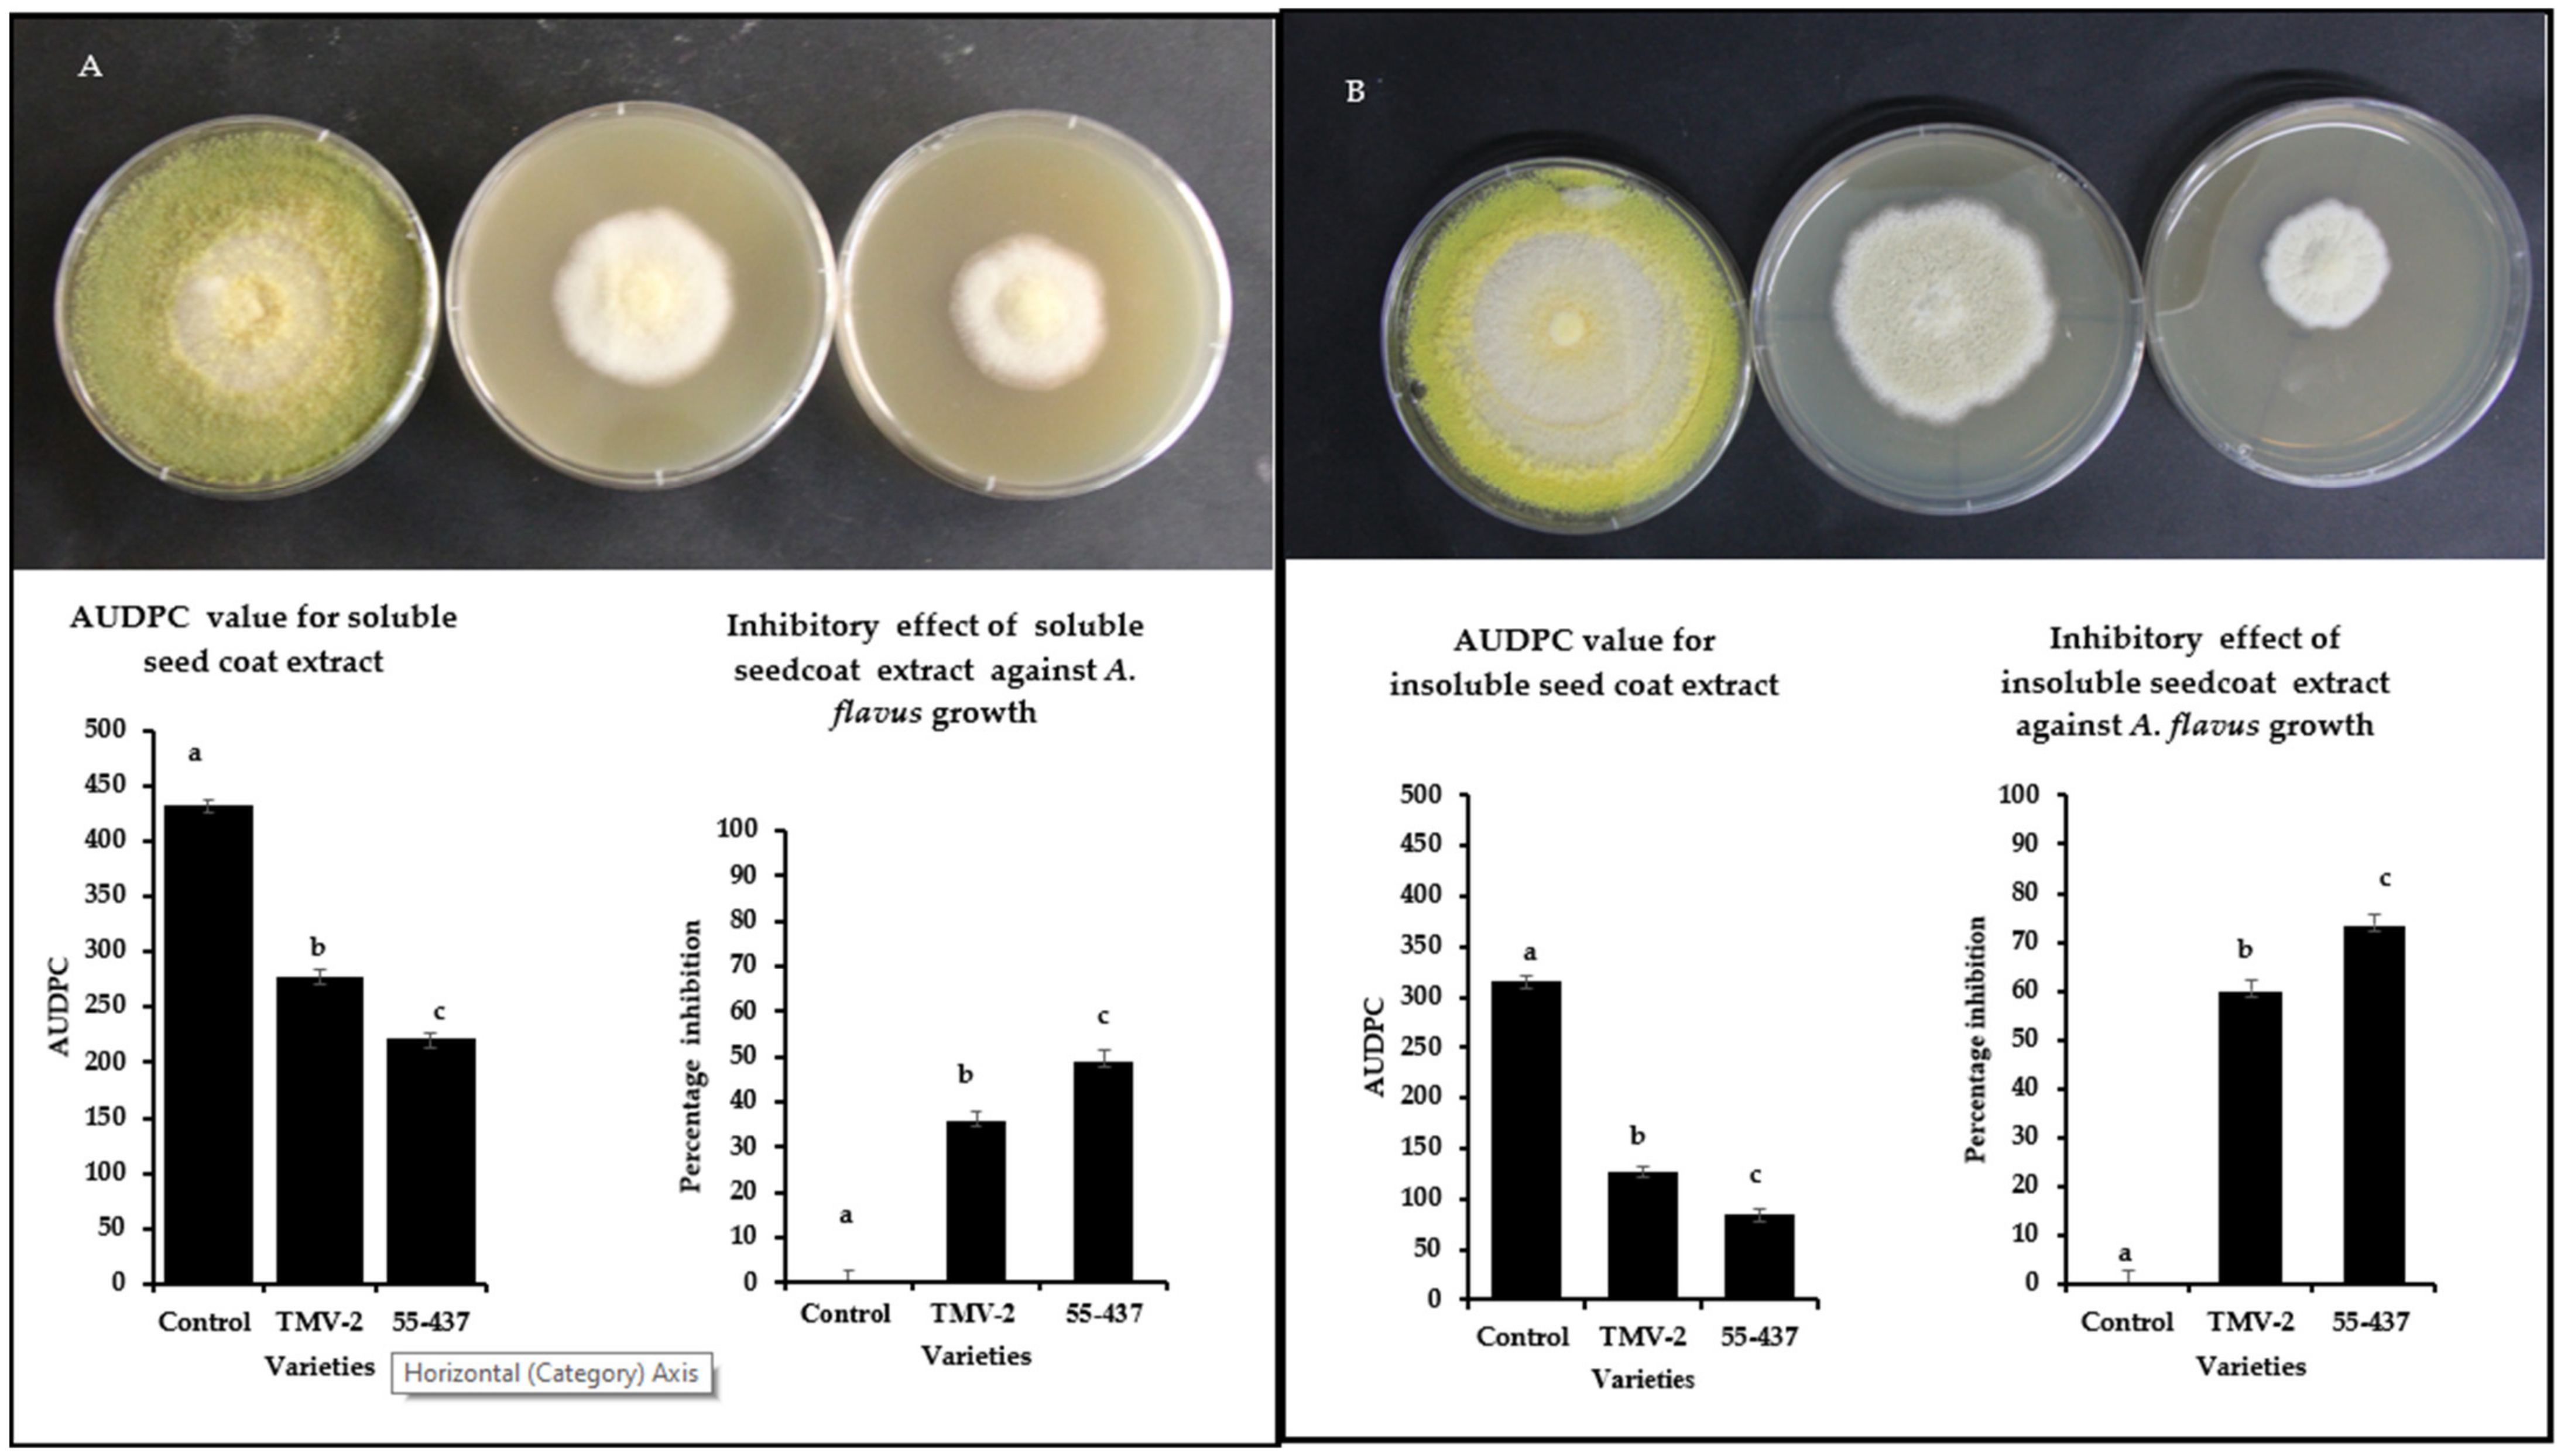
Jof 07 01000 g002

Peanut Seed Coat Acts as a Physical and Biochemical Barrier against Aspergillus flavus Infection
Abstract
:1. Introduction
2. Materials and Methods
2.1. Isolation and Characterization of A. flavus Isolates from Peanut
2.2. Morphological, Biochemical, and Molecular Characterization of A. flavus Isolates
2.3. DNA Extraction and PCR Analysis
2.4. Preparation of Fungal Cultures for Inoculation
2.5. In-Vitro Seed Colonization (IVSC) Assay
2.6. Estimation of A. flavus Growth in Inoculated Peanut Seeds
2.7. Chemical Reagents
2.8. Extraction of Soluble and Insoluble Phenolic Compounds from Peanut Seed Coats
2.9. Radial Growth Bioassay of Seed Coat Extracts Obtained from Peanut
2.10. Solid Phase Extraction and HPLC Analysis of Peanut Seed Coat Phenolic Acids
2.11. Antifungal Activity Assay of the Phenolic Acids
2.12. Determination of Total Lignin Content and Lignin Monomer Unit Contents of Peanut Seed Coat
2.13. Quantification of Soluble and Insoluble Tannin Present in Peanut Seed Coat
2.14. Gene Expression Analysis of Lignin- and Tannin-Related Genes in Peanut Seed Coat
2.15. Histological Analysis of Peanut Seed Coat Structure at the Developmental Stage
2.16. Statistical Analysis
3. Results
3.1. Identification and Characterization of Toxigenic A. flavus Isolate
3.2. Intact Seed Coat Reduces the A. flavus Infection
3.3. Peanut Seed Coat Phenolic Extracts Inhibited A. flavus Growth
3.4. Identification and Quantification of Phenolic Acids in the Peanut Seed Coat
3.5. Hydroxycinnamic Acid Derivates Inhibits A. flavus Growth on PDA Media
3.6. Resistant and Susceptible Lines Showed Differences in Tannins and Lignin Monomer Composition in Peanut Seed Coat
3.7. Phenylpropanoid Related Genes Showed Differential Expression Pattern between TMV-2 and 55-437
3.8. Peanut Seed Coat Developmental Biology Studies Showed Thick Outer and Innermost Layers with Compressed Inner Layers
4. Discussion
Supplementary Materials
Author Contributions
Funding
Institutional Review Board Statement
Informed Consent Statement
Data Availability Statement
Acknowledgments
Conflicts of Interest
References
- Eskola, M.; Kos, G.; Elliott, C.T.; Hajšlová, J.; Mayar, S.; Krska, R. Worldwide contamination of food-crops with mycotoxins: Validity of the widely cited ‘FAO estimate’of 25%. Crit. Rev. Food Sci. Nutr. 2020, 60, 2773–2789. [Google Scholar] [CrossRef] [PubMed]
- WHO; International Agency for Research on Cancer. Some naturally occurring substances: Food items and constituents, heterocyclic aromatic amines and mycotoxins. In IARC Monographs on the Evaluation of the Carcinogenic Risk of Chemicals to Humans; WHO: Geneva, Switzerland, 1993; Volume 56. [Google Scholar]
- Wu, F.; Groopman, J.D.; Pestka, J.J. Public health impacts of foodborne mycotoxins. Annu. Rev. Food Sci. Technol. 2014, 5, 351–372. [Google Scholar] [CrossRef] [PubMed] [Green Version]
- Awuchi, C.G.; Amagwula, I.O.; Priya, P.; Kumar, R.; Yezdani, U.; Khan, M.G. Aflatoxins in Foods and Feeds: A Review on Health Implications, Detection, and Control. Bull. Environ. Pharmacol. Life Sci. 2020, 9, 149–155. [Google Scholar]
- Min, W.-K.; Kweon, D.-H.; Park, K.; Park, Y.-C.; Seo, J.-H. Characterisation of monoclonal antibody against aflatoxin B1 produced in hybridoma 2C12 and its single-chain variable fragment expressed in recombinant Escherichia coli. Food Chem. 2011, 126, 1316–1323. [Google Scholar] [CrossRef]
- Emmott, A. Market-Led Aflatoxin Interventions: Smallholder Groundnut Value Chains in Malawi; International Food Policy Research Institute (IFPRI): Washington, DC, USA, 2013. [Google Scholar]
- Strosnider, H.; Azziz-Baumgartner, E.; Banziger, M.; Bhat, R.V.; Breiman, R.; Brune, M.-N.; DeCock, K.; Dilley, A.; Groopman, J.; Hell, K.; et al. Workgroup report: Public health strategies for reducing aflatoxin exposure in developing countries. Environ. Health Perspect. 2006, 114, 1898–1903. [Google Scholar] [CrossRef] [PubMed]
- N’dede, C.B.; Jolly, C.; Vodouhe, S.D.; Jolly, P. Economic risks of aflatoxin contamination in marketing of peanut in Benin. Econ. Res. Int. 2012, 2012, 12. [Google Scholar] [CrossRef]
- Faustinelli, P.C.; Wang, X.M.; Palencia, E.R.; Arias, R.S. Genome sequences of eight Aspergillus flavus spp. and one A. parasiticus sp., isolated from peanut seeds in Georgia. Genome Announc. 2016, 4, e00278-16. [Google Scholar] [CrossRef] [Green Version]
- Upadhyaya, H.D.; Ortiz, R.; Bramel, P.J.; Singh, S. Development of a groundnut core collection using taxonomical, geographical and morphological descriptors. Genet. Resour. Crop. Evol. 2003, 50, 139–148. [Google Scholar] [CrossRef]
- Sharma, K.K.; Pothana, A.; Prasad, K.; Shah, D.; Kaur, J.; Bhatnagar, D.; Chen, Z.Y.; Raruang, Y.; Cary, J.W.; Rajasekaran, K. Peanuts that keep aflatoxin at bay: A threshold that matters. Plant Biotechnol. J. 2018, 16, 1024–1033. [Google Scholar] [CrossRef] [Green Version]
- Hamidou, F.; Rathore, A.; Waliyar, F.; Vadez, V. Although drought intensity increases aflatoxin contamination, drought tolerance does not lead to less aflatoxin contamination. Field Crop. Res. 2014, 156, 103–110. [Google Scholar] [CrossRef] [Green Version]
- Lavkor, I.; Var, I. The control of aflatoxin contamination at harvest, drying, pre-storage and storage periods in peanut: The new approach. In Aflatoxin: Control, Analysis, Detection and Health Risks; IntechOpen: London, UK, 2017; pp. 45–64. [Google Scholar] [CrossRef] [Green Version]
- Nguyen, P.-A.; Strub, C.; Fontana, A.; Schorr-Galindo, S. Crop molds and mycotoxins: Alternative management using biocontrol. Biol. Control. 2017, 104, 10–27. [Google Scholar] [CrossRef]
- Ismail, A.; Gonçalves, B.L.; de Neeff, D.V.; Ponzilacqua, B.; Coppa, C.F.; Hintzsche, H.; Sajid, M.; Cruz, A.G.; Corassin, C.H.; Oliveira, C.A. Aflatoxin in foodstuffs: Occurrence and recent advances in decontamination. Food Res. Int. 2018, 113, 74–85. [Google Scholar] [CrossRef]
- Pandey, M.K.; Kumar, R.; Pandey, A.K.; Soni, P.; Gangurde, S.S.; Sudini, H.K.; Fountain, J.C.; Liao, B.; Desmae, H.; Okori, P.; et al. Mitigating Aflatoxin Contamination in Groundnut through A Combination of Genetic Resistance and Post-Harvest Management Practices. Toxins 2019, 11, 315. [Google Scholar] [CrossRef] [Green Version]
- Kabak, B.; Dobson, A.D.; Var, I.l. Strategies to prevent mycotoxin contamination of food and animal feed: A review. Crit. Rev. Food Sci. Nutr. 2006, 46, 593–619. [Google Scholar] [CrossRef]
- Zhao, Q.; Qiu, Y.; Wang, X.; Gu, Y.; Zhao, Y.; Wang, Y.; Yue, T.; Yuan, Y. Inhibitory Effects of Eurotium cristatum on Growth and Aflatoxin B1 Biosynthesis in Aspergillus flavus. Front. Microbiol. 2020, 11, 921. [Google Scholar] [CrossRef]
- Woodroof, J.G.; Leahy, J. Microscopical Studies of Peanuts with Reference to Processing; Georgia Experiment Station of the University System of Georgia: Atlanta, GA, USA, 1940. [Google Scholar]
- Zambettakis, C.; Bokelee, M. Research on the structure of the seed tegument of groundnut and its effect on the penetration of Aspergillus flavus. Oleagineux 1976, 31, 219–228. [Google Scholar]
- Zhou, G.Y.; Liang, X.Q. Studies on the ultramicroscopic structure of seedcoats between resistant and susceptible to Aspergillus flavus invasion in peanut. Chin. J. Oil Crop. Sci. 1999, 21, 32–35. [Google Scholar]
- Dieme, R.M.A.; Faye, I.; Zoclanclounon, Y.A.B.; Fonceka, D.; Ndoye, O.; Diedhiou, P.M. Identification of Sources of Resistance for Peanut Aspergillus flavus Colonization and Aflatoxin Contamination. Int. J. Agron. 2018, 2018, 5468602. [Google Scholar] [CrossRef] [Green Version]
- Chukwumah, Y.C.; Walker, L.T.; Verghese, M.; Ogutu, S. Effect of frequency and duration of ultrasonication on the extraction efficiency of selected isoflavones and trans-resveratrol from peanuts (Arachis hypogaea). Ultrason. Sonochem. 2009, 16, 293–299. [Google Scholar] [CrossRef]
- Shahidi, F.; Yeo, J. Insoluble-bound phenolics in food. Molecules 2016, 21, 1216. [Google Scholar] [CrossRef]
- Kim, J.H.; Campbell, B.C.; Mahoney, N.E.; Chan, K.L.; Molyneux, R.J. Identification of Phenolics for Control of Aspergillus flavus Using Saccharomyces cerevisiae in a Model Target-Gene Bioassay. J. Agric. Food Chem. 2004, 52, 7814–7821. [Google Scholar] [CrossRef]
- Pitt, J.; Hocking, A. Fungi and Food Spoilage; Blackie Academic and Professional: London, UK, 1997; Volume 2. [Google Scholar]
- Ordaz, J.J.; Fente, C.; Vázquez, B.; Franco, C.; Cepeda, A. Development of a method for direct visual determination of aflatoxin production by colonies of the Aspergillus flavus group. Int. J. Food Microbiol. 2003, 83, 219–225. [Google Scholar] [CrossRef]
- Fente, C.; Ordaz, J.J.; Vazquez, B.; Franco, C.; Cepeda, A. New additive for culture media for rapid identification of aflatoxin-producing Aspergillus strains. Appl. Environ. Microbiol. 2001, 67, 4858–4862. [Google Scholar] [CrossRef] [Green Version]
- Abbas, H.K.; Shier, W.; Horn, B.; Weaver, M. Cultural methods for aflatoxin detection. J. Toxicol. Toxin Rev. 2004, 23, 295–315. [Google Scholar] [CrossRef]
- Morris, S.; Nicholls, J. An evaluation of optical density to estimate fungal spore concentrations in water suspensions. Strain 1978, 1, 1240–1242. [Google Scholar] [CrossRef]
- Balasubramanian, V.K.; Rai, K.M.; Thu, S.W.; Hii, M.M.; Mendu, V. Genome-wide identification of multifunctional laccase gene family in cotton (Gossypium spp.); expression and biochemical analysis during fiber development. Sci. Rep. 2016, 6, 34309. [Google Scholar] [CrossRef] [Green Version]
- Xu, B.J.; Chang, S. A comparative study on phenolic profiles and antioxidant activities of legumes as affected by extraction solvents. J. Food Sci. 2007, 72, S159–S166. [Google Scholar] [CrossRef]
- Uldahl, S.A.; Knutsen, G. Spore swelling and germination as a bioassay for the rapid screening of crude biological extracts for antifungal activity. J. Microbiol. Methods 2009, 79, 82–88. [Google Scholar] [CrossRef]
- Shaner, G.; Finney, R. The effect of nitrogen fertilization on the expression of slow-mildewing resistance in Knox wheat. Phytopathology 1977, 67, 1051–1056. [Google Scholar] [CrossRef] [Green Version]
- Bekker, T.; Kaiser, C.; vd Merwe, R.; Labuschagne, N. In-vitro inhibition of mycelial growth of several phytopathogenic fungi by soluble potassium silicate. S. Afr. J. Plant Soil 2006, 23, 169–172. [Google Scholar] [CrossRef] [Green Version]
- Robinson, A.R.; Mansfield, S.D. Rapid analysis of poplar lignin monomer composition by a streamlined thioacidolysis procedure and near-infrared reflectance-based prediction modeling. Plant J. 2009, 58, 706–714. [Google Scholar] [CrossRef]
- Dixon, R.A.; Xie, D.Y.; Sharma, S.B. Proanthocyanidins—A final frontier in flavonoid research? New Phytol. 2005, 165, 9–28. [Google Scholar] [CrossRef] [PubMed] [Green Version]
- Rao, X.; Huang, X.; Zhou, Z.; Lin, X. An improvement of the 2ˆ(–delta delta CT) method for quantitative real-time polymerase chain reaction data analysis. Biostat. Bioinform. Biomath. 2013, 3, 71. [Google Scholar]
- Boote, K. Growth stages of peanut (Arachis hypogaea L.). Peanut Sci. 1982, 9, 35–40. [Google Scholar] [CrossRef]
- Mendu, V.; Stork, J.; Harris, D.; DeBolt, S. Cellulose synthesis in two secondary cell wall processes in a single cell type. Plant Signal. Behav. 2011, 6, 1638–1643. [Google Scholar] [CrossRef] [PubMed] [Green Version]
- Beeckman, T.; De Rycke, R.; Viane, R.; Inzé, D. Histological study of seed coat development in Arabidopsis thaliana. J. Plant Res. 2000, 113, 139–148. [Google Scholar] [CrossRef]
- Mitchell, N.J.; Bowers, E.; Hurburgh, C.; Wu, F. Potential economic losses to the US corn industry from aflatoxin contamination. Food Addit. Contam. Part A 2016, 33, 540–550. [Google Scholar] [CrossRef] [PubMed]
- Liu, Y.; Wu, F. Global burden of aflatoxin-induced hepatocellular carcinoma: A risk assessment. Environ. Health Perspect. 2010, 118, 818–824. [Google Scholar] [CrossRef] [Green Version]
- Hawkins, N.J.; Bass, C.; Dixon, A.; Neve, P. The evolutionary origins of pesticide resistance. Biol. Rev. 2019, 94, 135–155. [Google Scholar] [CrossRef]
- Alshannaq, A.F.; Gibbons, J.G.; Lee, M.-K.; Han, K.-H.; Hong, S.-B.; Yu, J.-H. Controlling aflatoxin contamination and propagation of Aspergillus flavus by a soy-fermenting Aspergillus oryzae strain. Sci. Rep. 2018, 8, 16871. [Google Scholar] [CrossRef]
- LaPrade, J.; Bartz, J.; Norden, A.; Demuynk, T. Correlation of peanut seed-coat surface wax accumulations with tolerance to colonization by Aspergillus flavus. J. Am. Peanut Res. Educ. Soc. 1973, 5, 89–94. [Google Scholar]
- Young, C.T.; Schadel, W.E. Microstructure of peanut seed: A review. Food Struct. 1990, 9, 3. [Google Scholar]
- Taber, R.; Pettit, R.; Benedict, C.; Dieckert, J.; Ketring, D. Comparison of Aspergillus flavus tolerant and susceptible peanut lines I. Light microscope investigation. J. Amer. Peanut. Res. Educ. Assoc. 1973, 5, 206–207. [Google Scholar]
- Schnur, S.E.; Amachawadi, R.G.; Baca, G.; Sexton-Bowser, S.; Rhodes, D.H.; Smolensky, D.; Herald, T.J.; Perumal, R.; Thomson, D.U.; Nagaraja, T.G. Antimicrobial Activity of Sorghum Phenolic Extract on Bovine Foodborne and Mastitis-Causing Pathogens. Antibiotics 2021, 10, 594. [Google Scholar] [CrossRef]
- Zheng, W.; Wang, S.Y. Antioxidant Activity and Phenolic Compounds in Selected Herbs. J. Agric. Food Chem. 2001, 49, 5165–5170. [Google Scholar] [CrossRef]
- Yu, J.; Ahmedna, M.; Goktepe, I. Effects of processing methods and extraction solvents on concentration and antioxidant activity of peanut skin phenolics. Food Chem. 2005, 90, 199–206. [Google Scholar] [CrossRef]
- De Camargo, A.C.; Regitano-d’Arce, M.A.B.; Rasera, G.B.; Canniatti-Brazaca, S.G.; do Prado-Silva, L.; Alvarenga, V.O.; Sant’Ana, A.S.; Shahidi, F. Phenolic acids and flavonoids of peanut by-products: Antioxidant capacity and antimicrobial effects. Food Chem. 2017, 237, 538–544. [Google Scholar] [CrossRef]
- Larrauri, M.; Zunino, M.P.; Zygadlo, J.A.; Grosso, N.R.; Nepote, V. Chemical characterization and antioxidant properties of fractions separated from extract of peanut skin derived from different industrial processes. Ind. Crop. Prod. 2016, 94, 964–971. [Google Scholar] [CrossRef]
- Win, M.M.; Abdul-Hamid, A.; Baharin, B.S.; Anwar, F.; Sabu, M.C.; Pak-Dek, M.S. Phenolic compounds and antioxidant activity of peanut’s skin, hull, raw kernel and roasted kernel flour. Pak. J. Bot. 2011, 43, 1635–1642. [Google Scholar]
- Chipley, J.; Uraih, N. Inhibition of Aspergillus growth and aflatoxin release by derivatives of benzoic acid. Appl. Environ. Microbiol. 1980, 40, 352–357. [Google Scholar] [CrossRef] [Green Version]
- Barral, B.; Chillet, M.; Minier, J.; Léchaudel, M.; Schorr-Galindo, S. Evaluating the response to Fusarium ananatum inoculation and antifungal activity of phenolic acids in pineapple. Fungal Biol. 2017, 121, 1045–1053. [Google Scholar] [CrossRef]
- Beekrum, S.; Govinden, R.; Padayachee, T.; Odhav, B. Naturally occurring phenols: A detoxification strategy for fumonisin B1. Food Addit. Contam. 2003, 20, 490–493. [Google Scholar] [CrossRef]
- Curir, P.; Dolci, M.; Dolci, P.; Lanzotti, V.; Cooman, L.D. Fungitoxic phenols from carnation (Dianthus caryophyllus) effective against Fusarium oxysporum f. sp. dianthi. Phytochem. Anal. Int. J. Plant Chem. Biochem. Tech. 2003, 14, 8–12. [Google Scholar] [CrossRef]
- Sanders, T.H. Effect of variety, location and year on tannin content of peanut seed coats. Peanut Sci. 1979, 6, 62–64. [Google Scholar] [CrossRef]
- Azaizeh, H.A.; Pettit, R.E.; Sarr, B.A.; Phillips, T.D. Effect of peanut tannin extracts on growth of Aspergillus parasiticus and aflatoxin production. Mycopathologia 1990, 110, 125–132. [Google Scholar] [CrossRef]
- Lima, R.B.; Salvador, V.H.; dos Santos, W.D.; Bubna, G.A.; Finger-Teixeira, A.; Soares, A.R.; Marchiosi, R.; Ferrarese, M.D.L.L.; Ferrarese-Filho, O. Enhanced lignin monomer production caused by cinnamic acid and its hydroxylated derivatives inhibits soybean root growth. PLoS ONE 2013, 8, e80542. [Google Scholar] [CrossRef]
- Wan, L.; Li, B.; Lei, Y.; Yan, L.; Huai, D.; Kang, Y.; Jiang, H.; Tan, J.; Liao, B. Transcriptomic profiling reveals pigment regulation during peanut testa development. Plant Physiol. Biochem. 2018, 125, 116–125. [Google Scholar] [CrossRef]
- Hu, M.; Li, J.; Hou, M.; Liu, X.; Cui, S.; Yang, X.; Liu, L.; Jiang, X.; Mu, G. Transcriptomic and metabolomic joint analysis reveals distinct flavonoid biosynthesis regulation for variegated testa color development in peanut (Arachis hypogaea L.). Sci. Rep. 2021, 11, 10721. [Google Scholar] [CrossRef] [PubMed]
- Huang, J.; Xing, M.; Li, Y.; Cheng, F.; Gu, H.; Yue, C.; Zhang, Y. Comparative transcriptome analysis of the skin-specific accumulation of anthocyanins in black peanut (Arachis hypogaea L.). J. Agric. Food Chem. 2019, 67, 1312–1324. [Google Scholar] [CrossRef] [PubMed]
- Zhao, X.; Li, C.; Yan, C.; Wang, J.; Yuan, C.; Zhang, H.; Shan, S. Transcriptome and proteome analyses of resistant preharvest peanut seed coat in response to Aspergillus flavus infection. Electron. J. Biotechnol. 2019, 39, 82–90. [Google Scholar] [CrossRef]

| Primer Name | Sequence | Gene Bank Accession Number |
|---|---|---|
| Aspergillus_ITS_F | CGGAAGGATCATTACCGAGT | AF138287.1 |
| Aspergillus_ITS_R | CCTACCTGATCCGAGGTCAA | |
| aflR_F | CTCAACGCCTCATGCTCATA | NW_002477243.1 |
| aflR_R | AGCTGCCACTGTTGGTTTCT | |
| aflE_norA_F | GGAGGAAGTGATGCGAAGTC | NW_002477243.1 |
| aflE_norA_R | GCTTGGGCACTGTTTCTAGC | |
| omtA_afLP_F | AGTTGGAATGTGCCTTCACC | NW_002477243.1 |
| omtA_afLP_R | GCGAATTCCACTCCTTGGTA | |
| aflM_F | CCGACAACCACCGTTTAGAT | NW_002477243.1 |
| aflM_R | GCTGACCTCGTCTACCTGCT | |
| aflD_nor-1_F | GGACGAGGTCTCATTGAAGC | NW_002477243.1 |
| aflD_nor-1_R | TGATCATACCCGAGCACAGA |
| Phenolic Acid | Retention Time (min) | Calibration Curve Equation | R2 | LOD (µg/mL) | LOQ (µg/mL) |
|---|---|---|---|---|---|
| Gallic acid | 10.36 | y = 62.359x + 725.89 | 0.9947 | 2.95 | 9.74 |
| Protocatechuic acid | 14.56 | y = 46.285x + 338.9 | 0.9986 | 8.88 | 26.92 |
| 4-Hydrobenezoic acid | 20.6 | y = 3.4162x + 2.2449 | 0.9997 | 3.74 | 11.33 |
| Caffeic acid | 24.9 | y = 23.06x − 53 | 0.9999 | 2.31 | 7.62 |
| Vanillic acid | 25.8 | y = 7.4772x + 128.03 | 0.9961 | 8.63 | 26.15 |
| Syringic acid | 32 | y = 7.8687x − 42.577 | 0.9973 | 2.5 | 8.25 |
| p-Coumaric acid | 38 | y = 11.729x + 27.184 | 0.9962 | 4.5 | 14.85 |
| Trans-O-Coumaric acid | 44 | y = 13.343x + 105.99 | 0.9979 | 3.4 | 11.22 |
| Ferulic acid | 47.56 | y = 3.9533x + 193.77 | 0.9814 | 2.8 | 9.24 |
| Sinapinic acid | 53.6 | y = 36.273 − 102.79 | 0.9999 | 2.07 | 6.29 |
| Primer Name | Sequence | Gene Bank Accession Number |
|---|---|---|
| CHS_F | TCGACTCGCGAAGGATCTTG | XM_016115652.1 |
| CHS_R | AACGGACGTTCCACTTTGGT | |
| CHI_F | TTCGTCAAGTTCACCGCCAT | XM_016086828.1 |
| CHI_R | CGGGGTCTTACCGTTCCATT | |
| F3H_F | CCACATTCCAAAATCCGGCA | XM_016325239.1 |
| F3H_R | CATCTCGGCGAAGGTGATCG | |
| DFR_F | TGCCACCAAGCCTTATCACT | XM_016117200.1 |
| DFR_R | TGAATGGTGGCTTCATGTGC | |
| LAR_F | ACACTAGCTGAGAAGGCTGC | XM_016329088.1 |
| LAR_R | TCTGGGGTGAGAGAAGGACC | |
| AHA10_F | AGCCATCCCCTACACCTGAT | XM_016350336.1 |
| AHA10_R | AGCCATGAGTCCTTGCAGAC | |
| CAD_F | ATTGGGGCTTGGTGGAGTTG | XM_016086511.1 |
| CAD_R | GGTGTCCAACAGGGACAGTG |
| Isolate | Fluorescence under UV | Remarks | |||
|---|---|---|---|---|---|
| PDA Media | YES Media | ||||
| Without B-Cyclodextrin | With B-Cyclodextrin | Without B-Cyclodextrin | With B-Cyclodextrin | ||
| A. flavus -1 | - | ++ | + | ++ | Toxigenic |
| A. flavus -2 | - | - | + | ++ | Toxigenic |
| A. flavus -3 | - | ± | + | ++ | Toxigenic |
| A. flavus -4 | - | - | + | ++ | Toxigenic |
| A. flavus -5 | - | - | - | - | Atoxigenic |
| A. flavus -6 | - | - | ++ | ++ | Toxigenic |
| A. flavus -7 | - | - | ++ | ++ | Toxigenic |
| A. flavus -8 | - | - | - | ++ | Toxigenic |
| Isolate | Aflatoxin Producing Genes | |||||
|---|---|---|---|---|---|---|
| aflE | aflD | aflQ | aflR | aflM | omt | |
| A. flavus -1 | + | + | + | + | + | + |
| A. flavus -2 | + | + | + | + | + | + |
| A. flavus -3 | + | + | + | + | + | + |
| A. flavus -4 | + | - | + | + | + | + |
| A. flavus -5 | - | - | - | + | - | - |
| A. flavus -6 | + | + | + | + | - | + |
| A. flavus -7 | + | - | - | - | + | - |
| A. flavus -8 | + | - | - | + | + | + |
Publisher’s Note: MDPI stays neutral with regard to jurisdictional claims in published maps and institutional affiliations. |
© 2021 by the authors. Licensee MDPI, Basel, Switzerland. This article is an open access article distributed under the terms and conditions of the Creative Commons Attribution (CC BY) license (https://creativecommons.org/licenses/by/4.0/).
Share and Cite
Commey, L.; Tengey, T.K.; Cobos, C.J.; Dampanaboina, L.; Dhillon, K.K.; Pandey, M.K.; Sudini, H.K.; Falalou, H.; Varshney, R.K.; Burow, M.D.; et al. Peanut Seed Coat Acts as a Physical and Biochemical Barrier against Aspergillus flavus Infection. J. Fungi 2021, 7, 1000. https://doi.org/10.3390/jof7121000
Commey L, Tengey TK, Cobos CJ, Dampanaboina L, Dhillon KK, Pandey MK, Sudini HK, Falalou H, Varshney RK, Burow MD, et al. Peanut Seed Coat Acts as a Physical and Biochemical Barrier against Aspergillus flavus Infection. Journal of Fungi. 2021; 7(12):1000. https://doi.org/10.3390/jof7121000
Chicago/Turabian StyleCommey, Leslie, Theophilus K. Tengey, Christopher J. Cobos, Lavanya Dampanaboina, Kamalpreet K. Dhillon, Manish K. Pandey, Hari Kishan Sudini, Hamidou Falalou, Rajeev K. Varshney, Mark D. Burow, and et al. 2021. "Peanut Seed Coat Acts as a Physical and Biochemical Barrier against Aspergillus flavus Infection" Journal of Fungi 7, no. 12: 1000. https://doi.org/10.3390/jof7121000
APA StyleCommey, L., Tengey, T. K., Cobos, C. J., Dampanaboina, L., Dhillon, K. K., Pandey, M. K., Sudini, H. K., Falalou, H., Varshney, R. K., Burow, M. D., & Mendu, V. (2021). Peanut Seed Coat Acts as a Physical and Biochemical Barrier against Aspergillus flavus Infection. Journal of Fungi, 7(12), 1000. https://doi.org/10.3390/jof7121000

